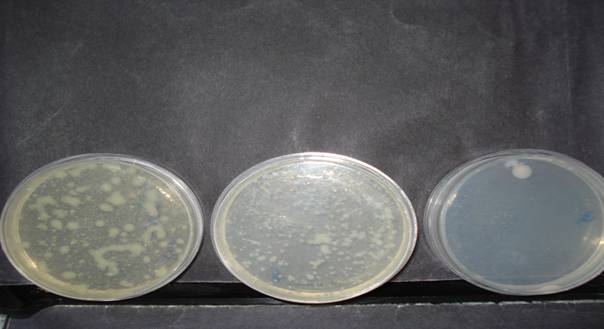
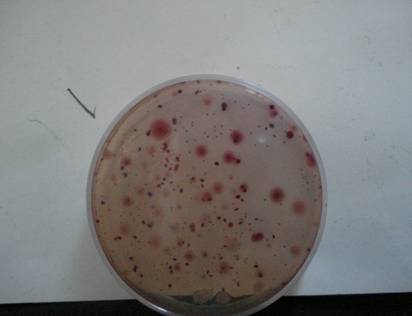

ESTUDIO DE COMPORTAMIENTO MICROBIOLÓGICO DE DISPENSER INSTALADO
INTRODUCCIÓN
Desde hace mucho tiempo se conoce la importancia de las enfermedades transmitidas por el agua, las principales causas de las patologías entéricas del hombre son los microorganismos patógenos. Por ello cada vez es más común la comercialización de agua tratada y envasada. Una de las maneras de proveer esta agua es a través de dispensers diseñados para obtener agua fría y caliente. En la actualidad es masivo su uso tanto en establecimientos públicos como privados.
El CAA regula los parámetros microbiológicos para agua envasada potable art 983. Debido a la ausencia de referencias microbiológicas de aguas dispensadas a través del equipo, se realiza este estudio para determinar la presencia y número de microorganismos indicadores causada por el uso continuo del mismo.
MATERIAL Y MÉTODOS
Se diseñó un protocolo de muestreo en una empresa del rubro metal mecánica seleccionándose 4 áreas elegidas según nivel sociocultural del personal usuario y calidad del medioambiente en el cual se encuentra el dispenser.
Se colocaron 4 dispensers de testeo sanitizados e identificados con un número de registro en: Guardia Ingreso (GI), Área Administrativa(AA), Taller (T) y sector Pintura (P) respectivamente.
Se destinaron para cada dispenser 4 bidones de 20 lt del mismo lote identificados. El día de instalación (muestreo 1, tabla 1), se colocó uno de los 4 bidones en cada equipo y se tomaron muestras de cada uno de ellos dejando correr aproximadamente 1,5 lts de agua. A partir de allí se enviaron grupos de bidones identificados para reponer su consumo.
Al tercer día (muestreo 2, tabla 2) se sacaron 2 muestras en cada puesto, uno directo de presión de grifo (D) y la segunda haciendo correr aproximadamente 1,5 lts de agua (L), previa desinfección del grifo.
Al cabo de ocho días de uso se vuelve a analizar (muestreo 3, tabla 3) idem a anterior.
En una última etapa del muestreo a los 20 días de inicio (muestreo 4, tabla 4) se procedió de la siguiente manera:
a) Se sanitizó el equipo (anexo ), sacando luego la muestra correspondiente. (sector GI).
b) Se realizó hisopado de superficie de bidón sin usar almacenado al lado del equipo e hisopado del interior del embudo del dispenser. (sector P).
c) se sacó muestra de grifo desinfectado, luego se retiró bidón en uso, se sacó tapa del mismo, se sanitizó parte externa y pico de bidón, rociando con solución de alcohol al 70% y se retiró muestra luego de haber vertido aproximadamente 1,5 lts agua. (sector T)
En todos los casos, desde el inicio del estudio, se evaluó una muestra adicional de un bidón cerrado tomado al azar como control de cada lote de los bidones enviados, dando parámetros normales según CAA.
La metodología de análisis fue la siguiente:
- recuento de bacterias Mesófilas Aerobias Totales/ ml. Medio PCA 37° C 24hs
- recuento coliformes totales por medio Agar Mac. Conkey filtración de membrana 37° C 48hs
- Presencia/ausencia de Escherichia coli/100ml. Medio Endo C. – Filtración de membrana 45° C 48hs
- Presencia/ausencia de Pseudomonas/100ml. Medio Cetrimida Filtración de membrana 37°C 48hs
- Para tipificación de Pseudomonas se utilizó Medio Agar F y Agar P (King B y King A)
RESULTADOS
TABLA 1 (MUESTREO 1)
FECHA |
MUESTREO |
ubicación |
equipo |
lote |
MESOFILAS |
COLIFORMES TOTALES |
ESCHERICHIA COLI |
PSEUDOMO- |
06/10 |
1 |
GI |
538 |
05/10 |
1 |
0 |
Ausencia |
Ausencia |
06/10 |
1 |
P |
148 |
05/10 |
460 |
0 |
Ausencia |
Presencia |
06/10 |
1 |
T |
537 |
05/10 |
2 |
0 |
Ausencia |
Ausencia |
06/10 |
1 |
AA |
246 |
05/10 |
38 |
0 |
Ausencia |
Presencia |
TABLA 2 (MUESTREO 2)
FECHA |
MUESTREO |
ubicación |
equipo |
lote |
MESOFILAS |
COLIFORMES TOTALES |
ESCHERICHIA COLI |
PSEUDOMO- |
|||||||
D |
L |
D |
L |
D |
L |
D |
L |
|
|||||||
09/10 |
2 |
GI |
538 |
05/10 |
20 |
5 |
0 |
0 |
Aus- |
Aus- |
Aus- |
Aus- |
|
||
09/10 |
2 |
P |
148 |
05/10 |
> |
> |
0 |
0 |
Aus- |
Aus- |
Pres |
Pres |
|
||
09/10 |
2 |
T |
537 |
05/10 |
50 |
200 |
0 |
0 |
Aus- |
Aus- |
Aus- |
Pres |
|
||
09/10 |
2 |
AA |
246 |
05/10 |
1000 |
> |
0 |
0 |
Aus- |
Aus- |
Aus- |
Pres |
|
||
TABLA 3 (MUESTREO 3)
FECHA |
MUESTREO |
ubicación |
equipo |
lote |
MESOFILAS |
COLIFORMES TOTALES |
ESCHERICHIA COLI |
PSEUDOMO- |
|||||||
D |
L |
D |
L |
D |
L |
D |
L |
|
|||||||
14/10 |
3 |
GI |
538 |
09/10 |
> |
> |
0 |
0 |
Aus- |
Aus- |
Aus- |
Pres |
|
||
14/10 |
3 |
P |
148 |
13/10 |
> |
> |
0 |
0 |
Aus- |
Aus- |
Pres |
Pres |
|
||
14/10 |
3 |
T |
537 |
13/10 |
> |
> |
0 |
0 |
Aus- |
Aus- |
Pres |
Pres |
|
||
14/10 |
3 |
AA |
246 |
05/10 |
> |
> |
0 |
0 |
Aus- |
Aus- |
Pres |
Pres |
|
||
TABLA 4 (MUESTREO 4)
FECHA |
MUESTREO |
ubicación |
equipo |
lote |
MESOFILAS |
COLIFORMES TOTALES |
ESCHERICHIA COLI |
PSEUDOMO- |
26/10 |
4 |
GI |
538 |
13/10 |
1 |
0 |
Ausencia |
Ausencia |
26/10 |
4 |
P |
148 |
20/10 |
2400 |
0 |
Ausencia |
Presencia |
300 |
0 |
Ausencia Hisopado interior embudo dispenser |
Ausencia |
|||||
26/10 |
4 |
T |
537 |
20/10 |
10000 |
0 |
Ausencia |
Ausencia |
10000 |
0 |
Ausencia |
Ausencia |

recuentos de mesòfilas (diluciones)

coliformes totales
De acuerdo a los valores reflejados en tabla 1 se observa la presencia de Pseudomonas ssp. A partir de los resultados de tablas 2 y 3 se observa el incremento de bacterias Mesófilas Totales y presencia continua de Pseudomonas. En tabla 4 se observa la presencia de pseudomonas y Mesófilas Totales en el hisopado externo del bidón previo a la colocación en el dispenser.
DISCUSIÓN:
Teniendo en cuenta los valores observados y las técnicas empleadas de sanitizado de los dispenser, se evidencia la necesidad de este proceso para mantener la calidad microbiológica del agua. Otro parámetro importante observado en este trabajo es la presencia de Pseudomonas y gran número de Mesófilas totales en el hisopado externo del bidón lo cual demuestra la influencia del ambiente y la manipulación del mismo, ya que la zona del pico, al colocarlo en el dispenser, está en contacto en el embudo con el agua y al accionar los grifos, el burbujeo producido puede provocar el ingreso de los microorganismos al bidón, contaminándolo, como lo evidencia el muestreo de la tabla 4 área T.
Esto trae como consecuencia la importancia de la capacitación del personal encargado de la reposición del agua en cuanto a lavado de manos, higienización (sanitizado) del bidón en su parte externa antes de su colocación.
El tratar de asegurar la asepsia externa del bidón con colocación de bolsa o film, etc, no sería eficaz si no se tienen en cuenta las pautas de manipulación anteriormente citadas.
CONCLUSIÓN
De acuerdo a los resultados obtenidos en este estudio inferimos que la contaminación proviene en su totalidad de la manipulación que se realiza en la acción de cambio de bidones en el dispenser.
Algunas de las soluciones que podrían implementarse para evitar esta contaminación sería impedir el contacto del agua que queda en el reservorio del dispenser, con la parte externa del bidón (entendiéndose pico del bidón).
Una información aportada por la bióloga Cecilia Guzmán de la U.N.C. F.Cs.E.F.yN, que observó en España, es el desarrollo experimental de un sistema de dispenser con bidones en forma horizontal evitando de esta manera el contacto con el agua.
Otra solución es la sanitización del bidón antes de su colocación, el previo lavado de manos del manipulador de esta acción y la limpieza periódica del dispenser, según sugerencia del proveedor.
Si bien el agua del bidón cerrado cumple con los parámetros microbiológicos establecidos por CAA, si no se tiene en cuenta la correcta manipulación de bidones y dispenser por parte del usuario, el consumidor no ingeriría un agua inocua.
ANEXO (Sanitizado de Dispenser)
. retire el bidón vacío
. vacíe el recipiente a través de las canillas
. límpielo con una esponja nueva, no abrasiva
. no utilice productos limpiadores
. enjugue con agua del bidón
. llene el recipiente del dispenser con agua del bidón
. agregue 15 gotas de hipoclorito
. deje actuar 8 minutos
. vacíe por ambas canillas
. enjuague con agua del bidón
. coloque el bidón lleno previo retiro del
precinto de seguridad de la tapa y su sanitizado externo (rociado con solución de alcohol al 70%)
BIBLIOGRAFÍA:
- Código Alimentario Argentino – art. 982- 983
- Corrie Allaert VANDEVENNE “Métodos de análisis microbiológicos de los alimentos”
- Mª del Rosario PASCUAL ANDERSON- Microbiología Alimentaria-“Métodos analíticos para Alimentos y Bebidas
Bioq. Marìa M. Virzi MP: 2258
Bioquímica especialista en bromatologia CE: 266
Laboratorio Bromatologico Dra Marìa Virzi- Gaona 1451-Los Plàtanos-Cba.
Ing. Eliam Molina
Ingeniera Química Industrial
M.P. 17534485
